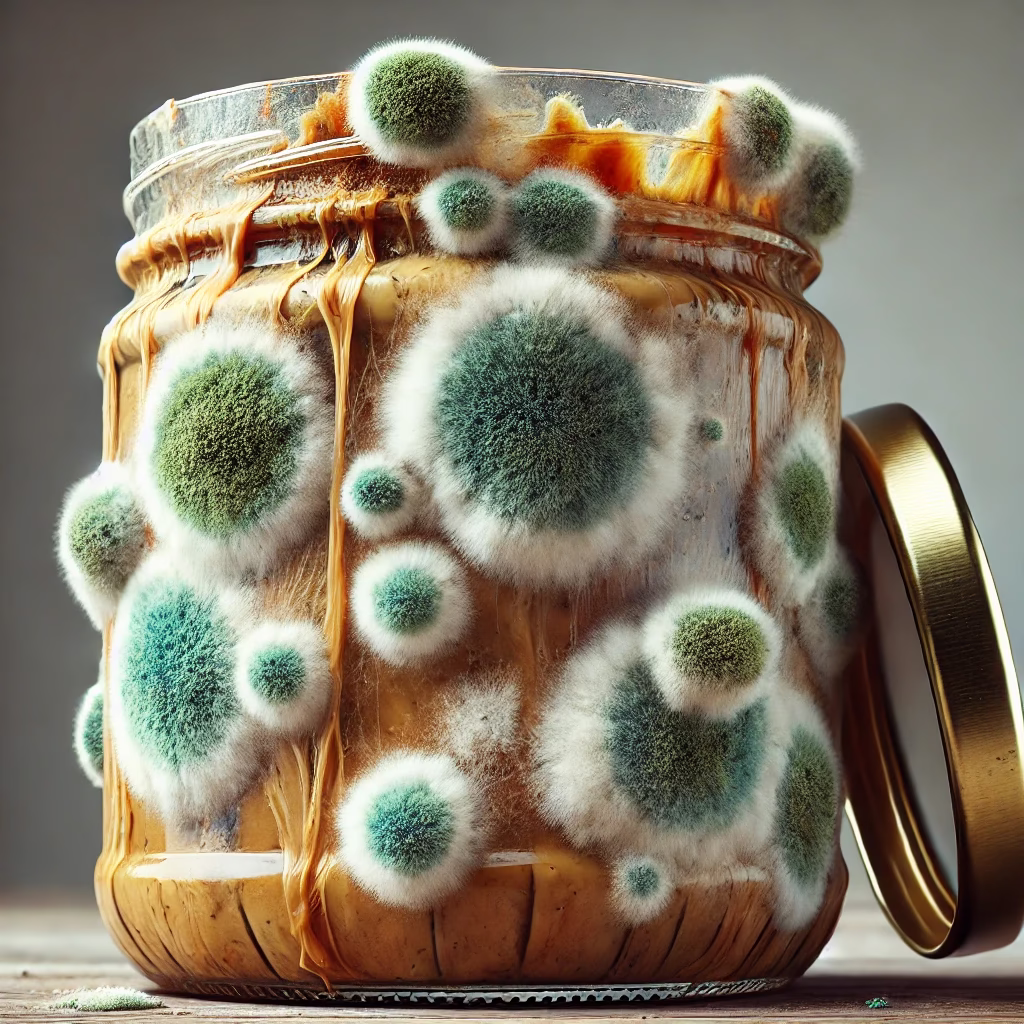
بهترین روش نگهداری کره بادام زمینی در خانه

کره بادامزمینی یکی از محبوبترین و پرخاصیتترین محصولات غذایی است که در سرتاسر دنیا طرفداران زیادی دارد. با توجه به ارزش غذایی بالای این محصول، لازم است بدانیم بهترین روش نگهداری کره بادام زمینی در خانه چیست تا بتوانیم از کیفیت، طعم و خواص آن بهدرستی بهرهمند شویم. در این مقاله جامع، نکات علمی و کاربردی برای نگهداری صحیح کره بادامزمینی را بررسی خواهیم کرد.
فهرست محتوا
🥶 نگهداری در یخچال یا دمای اتاق؟
نوع کره بادام زمینی نقش مهمی در روش نگهداری آن ایفا میکند.
- کره بادام زمینی طبیعی و ارگانیک (فاقد مواد نگهدارنده): بهتر است در یخچال نگهداری شود. چربیهای مفید موجود در این نوع کره در معرض گرما و نور، به سرعت اکسید شده و فاسد میشوند.
- کره بادامزمینی صنعتی: به دلیل وجود مواد افزودنی، امکان نگهداری آن در دمای محیط (حداکثر ۲۵ درجه) برای مدت کوتاه وجود دارد.

بیشتر بدانید: دانستنی های جذاب در مورد کره بادام زمینی
🌡️ دمای ایدهآل نگهداری کره بادام زمینی در خانه
بهترین دما برای نگهداری کره بادام زمینی در خانه بین ۴ تا ۸ درجه سانتیگراد است (دمای استاندارد یخچال). این دما مانع رشد میکروارگانیسمها و اکسیداسیون چربیها میشود.
نکته: در دمای پایین، بافت کره سفتتر میشود. برای استفاده راحت، چند دقیقه قبل از مصرف، آن را از یخچال خارج کرده و در دمای محیط قرار دهید.

بیشتر بدانید: بهترین کره بادام زمینی ایرانی
🧴 نوع بستهبندی مناسب
برای حفظ کیفیت کره بادامزمینی، نوع بستهبندی بسیار حائز اهمیت است:
- ظرف شیشهای دربدار بهترین گزینه است؛ از نفوذ هوا جلوگیری میکند.
- در ظروف پلاستیکی نگهداری نکنید؛ ممکن است مواد شیمیایی به چربی کره نفوذ کند.
- درب ظرف همیشه محکم بسته شود تا از تماس با رطوبت و اکسیژن جلوگیری گردد.

بیشتر بدانید: علت سفت شدن کره بادام زمینی چیست؟
⚠️ نکات مهم بهداشتی و ایمنی
رعایت بهداشت در نگهداری کره بادامزمینی اهمیت فراوانی دارد:
- از قاشق خشک و تمیز برای برداشتن کره استفاده کنید.
- هیچگاه قاشق آغشته به مواد غذایی یا خیس را وارد ظرف نکنید.
- ظرف را در مکانی خشک، تاریک و خنک قرار دهید.
- هرگز کره را در کنار منابع گرما یا نور مستقیم قرار ندهید.
🧪 نشانههای فساد کره بادام زمینی
چنانچه هر یک از موارد زیر را مشاهده کردید، کره فاسد شده و باید دور ریخته شود:
- بوی ترش یا سوخته
- تغییر رنگ به خاکستری یا سبز
- تغییر طعم به تلخی یا تندی
- وجود کپک یا لکههای سفید روی سطح
بیشتر بدانید: تاثیر استفاده از کره بادام زمینی در بازسازی عضلات پس از تمرین
🛑 اشتباهات رایج در نگهداری کره بادام زمینی در خانه
- نگهداری طولانیمدت در دمای اتاق
- استفاده از قاشق چرب یا آلوده
- قرار دادن ظرف در معرض نور
- عدم ثبت تاریخ باز شدن درب ظرف
- استفاده از ظروف پلاستیکی بازیافتی
💡 نکات کاربردی برای مصرف بهتر
- پس از باز شدن درب کره، آن را حداکثر تا ۶۰ روز در یخچال نگهداری کنید.
- اگر مصرف پایین دارید، میتوانید کره را به صورت پُرس شده در فریزر نگهداری کنید و هر بار یک پرس را استفاده نمایید.
- برای جلوگیری از جدا شدن روغن، پس از هر بار استفاده، کره را بهآرامی هم بزنید.
✅ نتیجهگیری
با رعایت نکاتی ساده اما کاربردی میتوان بهترین روش نگهداری کره بادام زمینی در خانه را اجرا کرد و از فاسد شدن یا تغییر طعم این ماده غذایی ارزشمند جلوگیری نمود. انتخاب محل مناسب، دمای استاندارد، ظرف بهداشتی و مراقبت روزمره، مهمترین فاکتورها برای حفظ کیفیت کره بادامزمینی در خانه هستند.
❓ سوالات متداول در مود بهترین روش نگهداری کره بادام زمینی در خانه
۱. کره بادام زمینی را در یخچال بگذاریم یا بیرون؟
اگر طبیعی باشد، حتماً در یخچال نگهداری شود؛ صنعتی را میتوان موقتاً بیرون نگه داشت.
۲. کره بادام زمینی چه مدت ماندگاری دارد؟
در یخچال تا ۲ ماه، در فریزر تا ۶ ماه.
۳. چطور بفهمیم کره خراب شده؟
از طریق بوی بد، طعم تلخ، تغییر رنگ و وجود کپک.
۴. چرا کره در یخچال سفت میشود؟
به دلیل دمای پایین؛ برای مصرف راحتتر، آن را کمی در محیط بگذارید.
۵. آیا میتوان کره بادام زمینی را در فریزر نگه داشت؟
بله، برای نگهداری طولانیتر کاملاً مناسب است.
برای دنبال کردن اینستاگرام ما کلیک کنید.